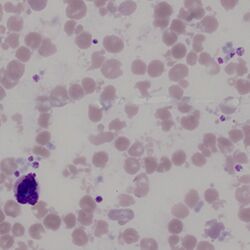

Microspherocytes
From haematologyetc.co.uk
Derivation: sphero – resembling sphere; micro - small
Appearance
Dense cells showing features of spherocytes, but with very reduced size. Evidence for the mechanism of formation may also be visible (see pathogenesis).
Images: Look for spherocytic cells with small size – there is no definite definition of micro in this context (and remember spherocytes are all small), but generally it seems reasonable to use a figure of less than half a normal red cell area. Note also that the true microspherocyte lacks central pallor – there is only one true microspherocyte on this field – the other very small cells have central pallor and are better regarded as rounded fragments (or may be referred to as "microdiscocytes"). There is also a true spherocyte which almost always are seen with microspherocytes. The clinical image simply show a microspherocyte
Significance
These cells are formed by the simultaneous loss of cell membrane and cell volume (i.e. contents are removed with the membrane elements). When these abnormal erythrocytes predominate, they are often the specific result of heat or toxic damage to erythrocytes; the appearance also arises in severe inherited conditions with instability of the erythrocyte cytoskeleton (pyropoikilocytosis). The cells may also be present as part of the spectrum of damaged cells in fragmentation syndromes.
Pitfalls
The cells are much smaller than typical spherocytes, so the distinction is generally easy – remember the absence of central pallor allows them to be distinguished from blunt fragmented cells. The key is to identify the primary pathology underlying their formation: either direct physical damage to red cells or membrane instability - the evidence for the primary pathological process will generally be present (remember also to consider artefactual causes such as a heated sample).
Causes
| Inherited defects |
|---|
| Severe membrane defects (e.g. hereditary pyropoikilocytosis) |
| Acquired causes with frequent microspherocytes |
| Direct physical damage to the erythrocyte membrane: burns or heated sample |
| Toxin induced membrane damage: particularly Clostridium perfringens |
| Acquired causes with infrequent microspherocytes |
| Infrequent microspherocytes may appear as part of a spectrum of cells in many conditions with erythrocyte damage (e.g. fragmentation) or fragile production (e.g. megaloblastic states) |
Clinical Examples
Clinical Image 1: There are numerous microspherocytes, together with evidence of budding from the membrane of intact erythrocytes. This occurs after heat damage e.g. burns – the microspherocytes will then be removed by the spleen over the next few hours leaving a profound anaemia. Clinical condition: acute burns
Clinical Image 2: Spherocytes, microspherocytes, elongated cells and more bizarre poikilocytes – again membrane instability. In this case the cause is an inherited defect of spectrin – when this defect is severe (or in homozygous form) a severe disturbance of erythrocyte shape results, but microspherocytes are a prominent feature. Named “hereditary pyropoikilocytosis” (after the resemblance to heat damage (hence pyro – fire)). Clinical condition: hereditary pyropoikilocytosis
Clinical Image 3':
Clinical condition: heated sample - the heating causes dissociation of spectrin fibrils and severe membrane instability (similar to burns); however in this case the effects of heating on normal white cells and platelets are also apparent (platelets are degranulated and clumped and white cells are degenerate).
Pathobiology
Following direct physical trauma e.g. heat or specific toxins, or where significant cytoskeletal defects lead to instability, the erythrocyte membrane may undergo “budding” where vesicles of cell membrane enclosing cell contents beak away from the main cell. The result is the presence of very small circulating spherocytic cells: microspherocytes. A similar mechanism may operate in red cell fragmentation syndromes.